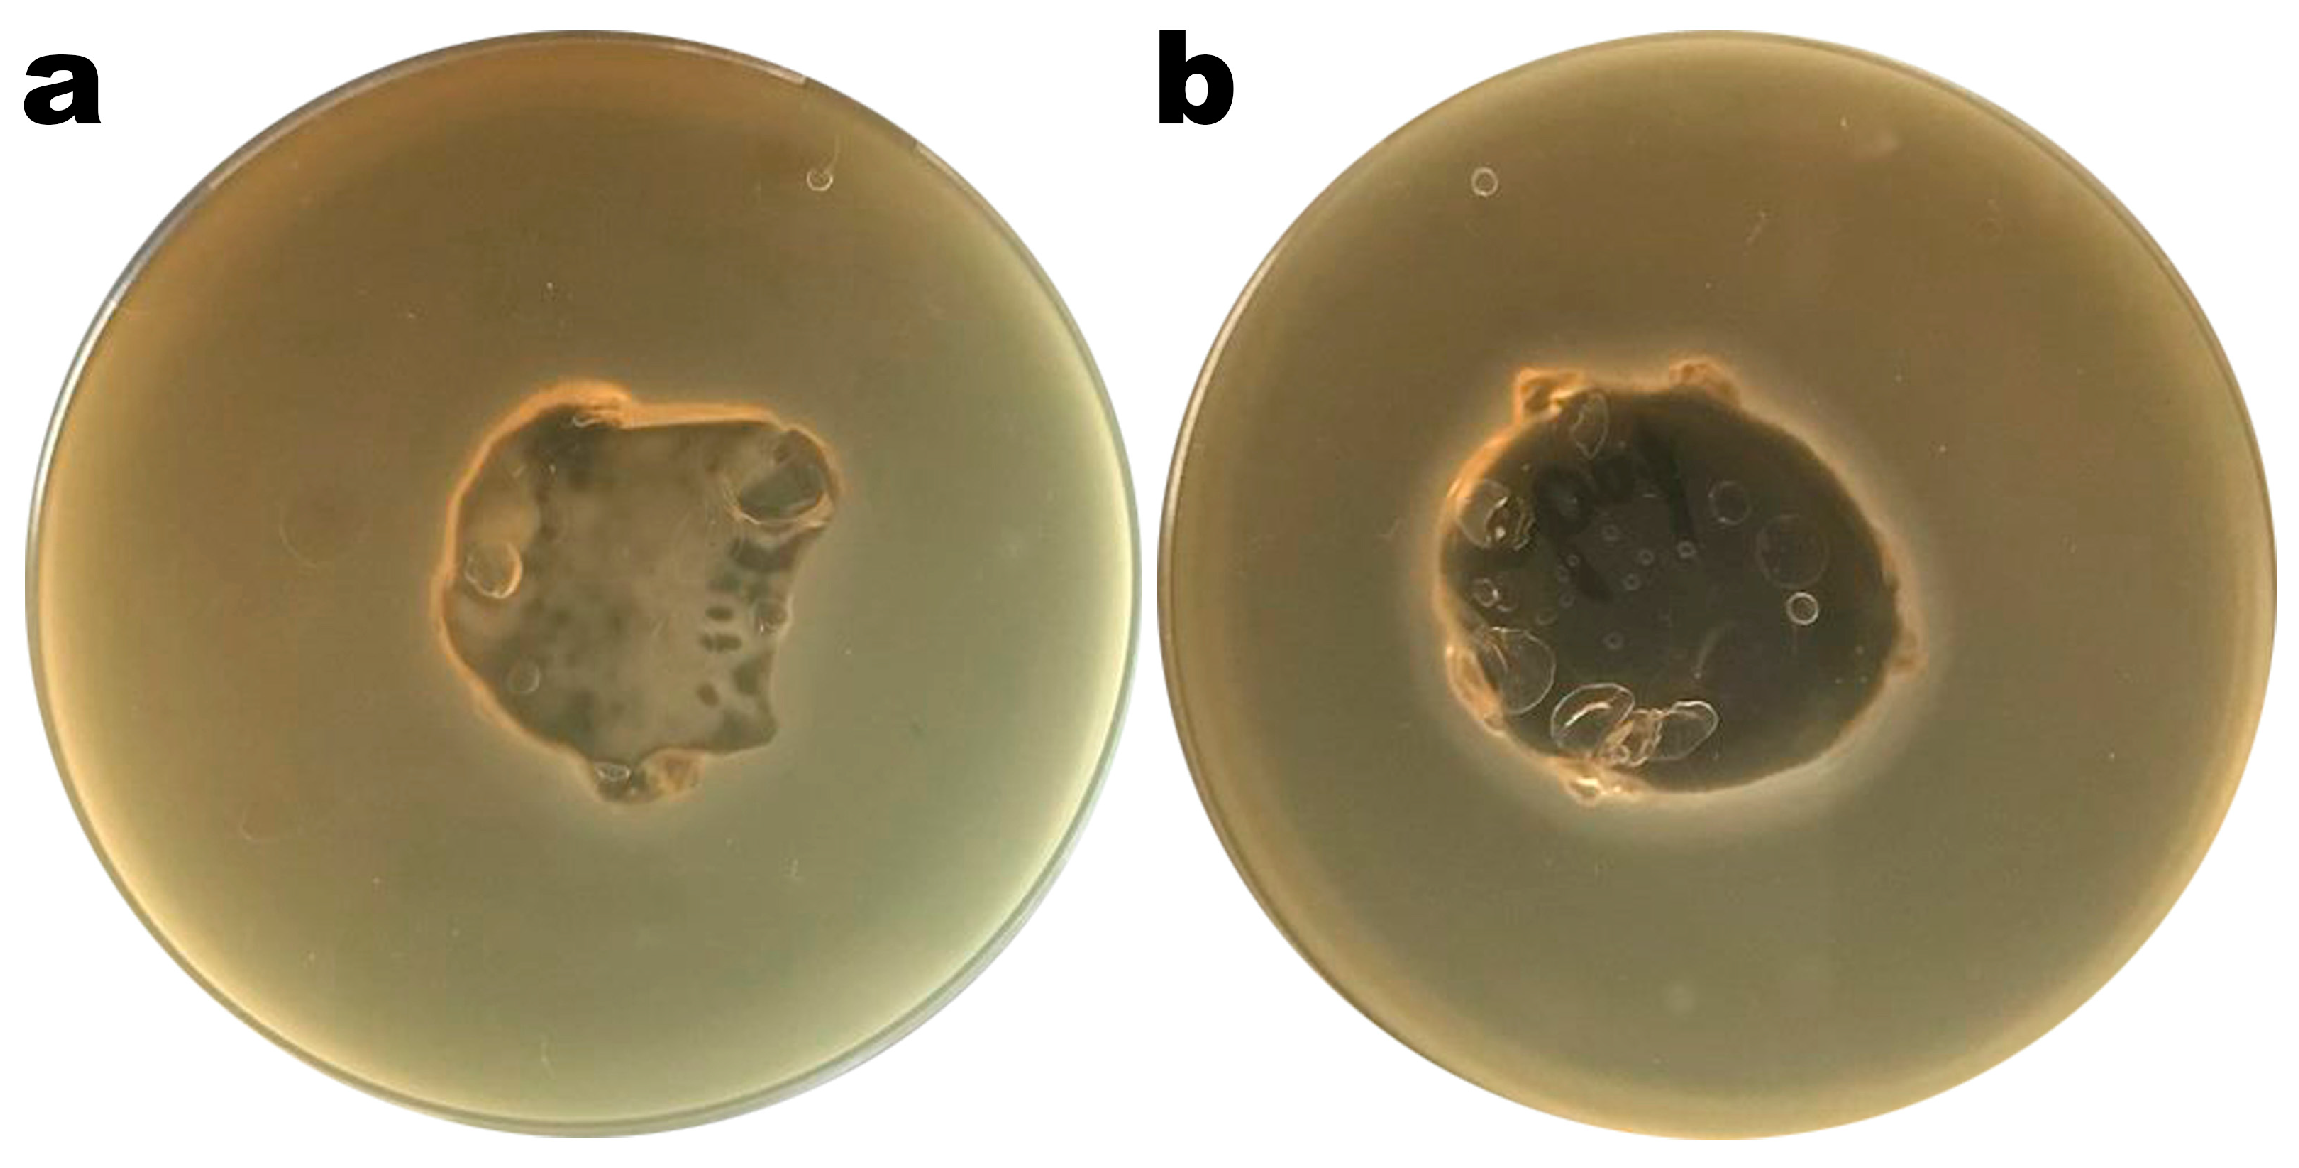
Polymers 16 00680 g004 Polymers 16 00680 g004

An Edible Antibacterial Coating Integrating Lytic Bacteriophage Particles for the Potential Biocontrol of Salmonella enterica in Ripened Cheese
Abstract
1. Introduction
2. Materials and Methods
2.1. Materials
2.1.1. Preparation of Culture Media, Solutions, and Laboratory Materials
2.1.2. Biological Materials
2.1.3. Chemicals
2.2. Experimental Procedures
2.2.1. Preparation of a Suitable Bacterial Suspension of Salmonella enterica CCCD-S004
2.2.2. Bacterial Lawns (Salmonella enterica CCCD-S004) Using the Pour Plate Technique
2.2.3. Spot Test Verification of Lytic Activity in the Two Phage Suspensions
2.2.4. Phage Virion PEG-Precipitation
2.2.5. Bacteriophage Enumeration
2.2.6. Transmission Electron Microscopy (TEM) Analyses
2.2.7. Sodium DodecylSulphate PolyAcrylamide Gel Electrophoresis (SDS-PAGE) Analysis of Phage Virion Structural Proteins
2.2.8. Formulation and Characterization of the Edible Antibacterial Coating (Ediphage) Integrating the Lytic Phage Cocktail
2.2.9. Statistical Analyses
3. Results and Discussion
3.1. Morphological Characteristics of the Bacteriophage Virions Via TEM Analyses
3.2. Structural Protein Profile of Phage Sents01l and Sents01t Virions Obtained through SDS-PAGE Analysis
3.3. Preparation and Characterization of the Edible Antibacterial Coating (Ediphage) Integrating the Lytic Bacteriophage Cocktail
4. Conclusions
Author Contributions
Funding
Institutional Review Board Statement
Data Availability Statement
Conflicts of Interest
References
- Ravi, Y.; Pooja, K.M.; Yadav, Y. Review-bacteriophages in food preservation. Int. J. Pure Appl. Biosci. 2017, 5, 197–205. [Google Scholar] [CrossRef]
- Anany, H.; Brovko, L.Y.; El-Arabi, T.; Griffiths, M.V. Bacteriophages as antimicrobials in food products: History, biology and application. In Handbook of Natural Antimicrobials for Food Safety and Quality, 1st ed.; Woodhead Publishing: Cambridge, UK, 2015; Chapter 4; pp. 69–87. [Google Scholar] [CrossRef]
- Finger, J.A.F.F.; Baroni, W.S.G.V.; Maffei, D.F.; Bastos, D.H.M.; Pinto, U.M. Overview of foodborne disease outbreaks in Brazil from 2000 to 2018. Foods 2019, 8, 434. [Google Scholar] [CrossRef]
- Feltes, M.M.C.; Arisseto-Bragotto, A.P.; Block, J.M. Food quality, food-borne diseases, and food safety in the brazilian food industry. Food Qual. Saf. 2017, 1, 13–27. [Google Scholar] [CrossRef]
- Eng, S.; Pusparajah, P.; Mutalib, N.A.; Ser, H.; Chan, K.; Lee, L. Salmonella: A review on pathogenesis, epidemiology and antibiotic resistance. Front. Life Sci. 2015, 8, 284–293. [Google Scholar] [CrossRef]
- Pulido-Landínez, M. Food safety—Salmonella update in broilers. Anim. Feed. Sci. Technol. 2019, 250, 53–58. [Google Scholar] [CrossRef]
- Moye, Z.D.; Woolston, J.; Sulakvelidze, A. Bacteriophage applications for food production and processing. Viruses 2018, 10, 205. [Google Scholar] [CrossRef] [PubMed]
- Zhang, H.; Tikekar, R.V.; Ding, Q.; Gilbert, A.R.; Wimsatt, S.T. Inactivation of foodborne pathogens by the synergistic combinations of food processing technologies and food-grade compounds. Compr. Rev. Food Sci. Food Saf. 2020, 19, 2110–2138. [Google Scholar] [CrossRef] [PubMed]
- Giannakourou, M.C.; Tsironi, T.N. Application of processing and packaging hurdles for fresh-cut fruits and vegetables preservation. Foods 2021, 10, 830. [Google Scholar] [CrossRef] [PubMed]
- Doss, J.; Culbertson, K.; Hahn, D.; Camacho, J.; Barekzi, N. A review of phage therapy against bacterial pathogens of aquatic and terrestrial organisms. Viruses 2017, 9, 50. [Google Scholar] [CrossRef] [PubMed]
- Garvey, M. Bacteriophages and food production: Biocontrol and bio-preservation options for food safety. Antibiotics 2022, 11, 1324. [Google Scholar] [CrossRef]
- Vikram, A.; Woolston, J.; Sulakvelidze, A. Phage biocontrol applications in food production and processing. Curr. Issues Mol. Biol. 2021, 40, 267–302. [Google Scholar] [CrossRef] [PubMed]
- Imran, A.; Shehzadi, U.; Islam, F.; Afzaal, M.; Ali, R.; Ali, Y.A.; Chauhan, A.; Biswas, S.; Khurshid, S.; Usman, I.; et al. Bacteriophages and food safety: An updated overview. Food Sci. Nutr. 2023, 11, 3621–3630. [Google Scholar] [CrossRef] [PubMed]
- Kazi, M.; Annapure, U.S. Bacteriophage biocontrol of foodborne pathogens. J. Food Sci. Technol. 2016, 53, 1355–1362. [Google Scholar] [CrossRef] [PubMed]
- Keen, E.C. A century of phage research: Bacteriophages and the shaping of modern biology. Bioessays 2015, 37, 6–9. [Google Scholar] [CrossRef] [PubMed]
- Sahu, R.; Singh, A.K.; Kumar, A.; Singh, K.; Kumar, P. Bacteriophages Concept and Applications: A Review on Phage Therapy. Curr. Pharm. Biotechnol. 2023, 24, 1245–1264. [Google Scholar] [CrossRef]
- Ioannou, P.; Baliou, S.; Samonis, G. Bacteriophages in Infectious Diseases and Beyond—A Narrative Review. Antibiotics 2023, 12, 1012. [Google Scholar] [CrossRef]
- Adams, M.H. Bacteriophages; Interscience Publishers: New York, NY, USA; London, UK, 1959; p. 592. [Google Scholar]
- Garcia, P.; Martínez, B.; Obeso, J.M.; Rodríguez, A. Bacteriophages and their application in food safety. Lett. Appl. Microbiol. 2008, 47, 479–485. [Google Scholar] [CrossRef]
- Sillankorva, S.M.; Oliveira, H.; Azeredo, J. Bacteriophages and their role in food safety. Int. J. Microbiol. 2010, 2012, 863945. [Google Scholar] [CrossRef]
- Pereira, A.O.; Barros, N.M.A.; Guerrero, B.R.; Emencheta, S.C.; Baldo, D.Â.; Oliveira Jr., J.M.; Vila, M.M.D.C.; Balcão, V.M. An edible biopolymeric microcapsular wrapping integrating lytic bacteriophage particles for Salmonella enterica: Potential for integration into poultry feed. Antibiotics 2023, 12, 988. [Google Scholar] [CrossRef] [PubMed]
- Silva, E.C.; Rodrigues, L.M.R.; Vila, M.M.D.C.; Balcão, V.M. Newly isolated phages preying on Pseudomonas syringae pv. garcae: In vitro and ex vivo inactivation studies in coffee plant leafs. Enzyme Microb. Technol. 2023, 171, 110325. [Google Scholar] [CrossRef] [PubMed]
- Balcão, V.M.; Moreira, A.R.; Moutinho, C.G.; Chaud, M.V.; Tubino, M.; Vila, M.M.D.C. Structural and functional stabilization of phage particles in carbohydrate matrices for bacterial biosensing. Enzyme Microb. Technol. 2013, 53, 55–69. [Google Scholar] [CrossRef]
- Balcão, V.M.; Barreira, S.V.P.; Nunes, T.M.; Chaud, M.V.; Tubino, M.; Vila, M.M.D.C. Carbohydrate hydrogels with stabilized phage particles for bacterial biosensing: Bacterium diffusion studies. Appl. Biochem. Biotechnol. 2014, 172, 1194–1214. [Google Scholar] [CrossRef]
- Łętocha, A.; Miastkowska, M.; Sikora, E. Preparation and Characteristics of Alginate Microparticles for Food, Pharmaceutical and Cosmetic Applications. Polymers 2022, 14, 3834. [Google Scholar] [CrossRef]
- Rocha, L.K.H.; Favaro, L.I.L.; Rios, A.C.; Silva, E.C.; Silva, W.F.; Stigliani, T.P.; Guilger, M.; Lima, R.; Oliveira, J.M.; Aranha, N.; et al. Sericin from Bombyx mori cocoons. Part I: Extraction and physicochemical-biological characterization for biopharmaceutical applications. Process Biochem. 2017, 61, 163–177. [Google Scholar] [CrossRef]
- Silva, E.C.; Oliveira, T.J.; Moreli, F.C.; Harada, L.K.; Vila, M.M.D.C.; Balcão, V.M. Newly isolated lytic bacteriophages for Staphylococcus intermedius, structurally and functionally stabilized in a hydroxyethylcellulose gel containing choline geranate: Potential for transdermal permeation in veterinary phage therapy. Res. Vet. Sci. 2020, 135, 42–58. [Google Scholar] [CrossRef] [PubMed]
- Balcão, V.M.; Belline, B.G.; Silva, E.C.; Almeida, P.F.F.B.; Baldo, D.Â.; Amorim, L.R.P.; Oliveira Júnior, J.M.; Vila, M.M.D.C.; Del Fiol, F.S. Isolation and molecular characterization of two novel lytic bacteriophages for the biocontrol of Escherichia coli in uterine infections: In vitro and ex vivo preliminary studies in veterinary medicine. Pharmaceutics 2022, 14, 2344. [Google Scholar] [CrossRef] [PubMed]
- Rogero, S.O.; Lugão, A.B.; Ikeda, T.I.; Cruz, A.S. Teste in vitro de citotoxicidade: Estudo comparativo entre duas metodologias [In vitro cytotoxicity test: Comparative study between two methodologies. Mater. Res. 2003, 6, 317–320. [Google Scholar] [CrossRef]
- Feldkamp, L.A.; Davis, L.C.; Kress, J.W. Practical cone-beam algorithm. J. Opt. Soc. Am. A 1984, 1, 612–619. [Google Scholar] [CrossRef]
- Manjula, B.; Varaprasad, K.; Sadiku, R.; Ray, K.M. Preparation and characterization of sodium alginate-based biohydrogels and their in vitro release studies. Adv. Polym. Technol. 2013, 32, 1–12. [Google Scholar] [CrossRef]
- De’Nobili, M.D.; Curto, L.M.; Delfino, J.M.; Pérez, C.D.; Bernhardt, D.; Gerschenson, L.N.; Fissore, E.N.; Rojas, A.M. Alginate utility in edible and nonedible film development and the influence of its macromolecular structure in the antioxidant activity of a pharmaceutical/food interface. In Alginic Acid: Chemical Structure, Uses and Health Benefits; Moore, A., Ed.; Chemistry Research and Applications Serie; Nova Science Publishers, Inc.: Hauppauge, NY, USA, 2014; Chapter 6; pp. 119–169. ISBN 978-1-63463-242-3. [Google Scholar]
- Alves, D.; Cerqueira, M.A.; Pastrana, L.M.; Sillankorva, S. Entrapment of a phage cocktail and cinnamaldehyde on sodium alginate emulsion-based films to fight food contamination by Escherichia coli and Salmonella enteritidis. Food Res. Int. 2020, 128, 108791. [Google Scholar] [CrossRef] [PubMed]
- Dicastillo, C.L.; Settier-Ramírez, L.; Gavara, R.; Hernández-Muñoz, P.; Carballo, G.L. Development of biodegradable films loaded with phages with antilisterial properties. Polymers 2021, 13, 327. [Google Scholar] [CrossRef]
- Fertah, M.; Belfkira, A.; Dahmane, E.; Taourirte, M.; Brouillette, F. Extraction and characterization of sodium alginate from Moroccan Laminaria digitata brown seaweed. Arab. J. Chem. 2017, 10, S3707–S3714. [Google Scholar] [CrossRef]
- Kushwaha, P. Metallic impurities in pharmaceuticals: An overview. Curr. Pharm. Anal. 2020, 17, 960–968. [Google Scholar] [CrossRef]
- Fernandes, R.S.; Moura, M.R.; Glenn, G.M.; Aouada, F.A. Thermal, microstructural, and spectroscopic analysis of Ca2+ alginate/clay nanocomposite hydrogel beads. J. Mol. Liq. 2018, 265, 327–336. [Google Scholar] [CrossRef]
- Daemi, H.; Barikan, M. Synthesis and characterization of calcium alginate nanoparticles, sodium homopolymannuronate salt and its calcium nanoparticles. Sci. Iran. 2012, 19, 2023–2028. [Google Scholar] [CrossRef]
- Helmiyati, K.; APrilliza, M. Characterization and Properties of Sodium Alginate from Brown Algae Used as an Ecofriendly Superabsorbent. In IOP Conference Series: Materials Science and Engineering; IOP Publishing: Bristol, UK, 2017; Volume 188, pp. 1–5. [Google Scholar] [CrossRef]
- Horowltz, S.; Trleve, R.C. Carbon-Oxygen hydrogen bonding in biological structure and function. J. Biol. Chem. 2012, 287, 41576–41582. [Google Scholar] [CrossRef]
- Laia, A.G.S.; Costa Jr, E.S.; Costa, H.S. A study of sodium alginate and calcium chloride interaction through films for intervertebral disc regeneration uses. In Proceedings of the 21 CBECIMAT—Congresso Brasileiro de Engenharia e Ciência dos Materiais, Cuiabá, MT, Brasil, 9–13 November 2014. [Google Scholar]
- Soares, J.P.; Santos, J.E.; Chierice, G.O.; Cavalheiro, E.T.G. Thermal behavior of alginic acid and its sodium salt. Eclética Quím. 2004, 29, 57–63. [Google Scholar] [CrossRef]
- Lopes, S.; Bueno, L.; Aguiar Júnior, F.; Finkler, C. Preparation and characterization of alginate and gelatin microcapsules containing Lactobacillus rhamnosu. An. Braz. Acad. Sci. 2017, 89, 1601–1613. [Google Scholar] [CrossRef]
- Chun, C.N.W.; Tajarudin, H.A.; Ismail, N.; Azahari, B.; Makhtar, M.M.Z. Elucidation of mechanical, physical, chemical and thermal properties of microbial composite films by integrating sodium alginate with Bacillus subtilis sp. Polymers 2021, 13, 2103. [Google Scholar] [CrossRef] [PubMed]
- Kim, N.A.; An, I.B.; Lim, D.G.; Lim, J.Y.; Lee, S.Y.; Shim, W.S.; Kang, N.; Jeong, S.H. Effects of pH and buffer concentration on the thermal stability of etanercept using DSC and DLS. Biol. Pharm. Bull. 2014, 77, 808–816. [Google Scholar] [CrossRef] [PubMed]
- Costa, M.J.; Marques, A.M.; Pastrano, L.M.; Teixeira, J.A.; Sillankova, S.M.; Cerqueira, M.A. Physicochemical properties of alginate-based films: Effect of ionic crosslinking and mannuronic and guluronic acid ratio. Food Hydrocoll. 2018, 81, 442–448. [Google Scholar] [CrossRef]
- Jiao, W.; Chen, W.; Mei, Y.; Yun, Y.; Wang, B.; Zhong, Q.; Chen, H.; Chen, W. Effects of molecular weight and guluronic acid/mannuronic Acid Ratio on the rheological behavior and stabilizing property of sodium alginate. Molecules 2019, 24, 4374. [Google Scholar] [CrossRef] [PubMed]
- Turbiani, F.R.B.; Kieckbusch, T.G.; Gimenes, M.L. Release of calcium benzoate from films of sodium alginate crosslinked with calcium ions. Polímeros 2011, 21, 175–181. [Google Scholar] [CrossRef][Green Version]
- Rodrigues, A.A.M.; Costa, R.R.; Santos, L.F.; Silva, S.M.; Britto, D.; Lima, M.A.C. Properties and characterization of biodegradable films obtained from different starch source. Food Sci. Technol. 2021, 51 (Suppl. S2), 1–7. [Google Scholar] [CrossRef]
- Matloob, A.; Ayub, H.; Mohsin, M.; Ambreen, S.; Khan, F.A.; Oranab, S.; Rahim, M.A.; Khalid, W.; Nayik, G.A.; Ramniwas, S.; et al. A review on edible coatings and films: Advances, composition, production methods, and safety concerns. ACS Omega 2023, 8, 28932–28944. [Google Scholar] [CrossRef] [PubMed]
- Janik, W.; Nowotarski, M.; Ledniowska, K.; Shyntum, D.Y.; Krukiewicz, K.; Turczyn, R.; Sabura, E.; Furgoł, S.; Kudła, S.; Dudek, G. Modulation of physicochemical properties and antimicrobial activity of sodium alginate films through the use of chestnut extract and plasticizers. Sci. Rep. 2023, 13, 11530. [Google Scholar] [CrossRef]
- Parreidt, T.S.; Müller, K.; Schmid, M. Alginate-based edible films and coatings for food packaging applications. Foods 2018, 7, 170. [Google Scholar] [CrossRef]
- Puscaselu, R.; Severin, T.L.; AmarieI, S. Use of biopolymers in designing edible packaging materials for food industry: Development of statistical models. Mater. Plast. 2019, 56, 199–204. [Google Scholar]
- Yang, T. Mechanical and Swelling Properties of Hydrogels, KTH Ytbehandlingsteknik. Ph.D. Thesis, Stockholm, Sweden, 2012; p. 77. Available online: http://www.diva-portal.org/smash/get/diva2:571374/FULLTEXT01.pdf (accessed on 17 December 2023).
- Gong, J.P.; Hong, W. Mechanics and physics of hydrogels. Soft. Matter. 2012, 8, 8006–8007. [Google Scholar]

| Component | EdiPhage Film Formulation | ||
|---|---|---|---|
| Formulation 1 (Plain EdiPhage) | Formulation 2 (EdiPhage Integrating the Lytic Phage Cocktail) | ||
| Phage cocktail [% (w/w); m (mg)] | Phage SentS01L [% (w/w); m (mg)] | - | 0.055; 55 µL |
| Phage SentS01T [% (w/w); m (mg)] | 0.055; 55 µL | ||
| Sodium alginate [% (w/w); m (mg)] | 1.50; 1500 | 1.50; 1500 | |
| CaCO3 22.5 mM [% (w/w); m (mg)] | 0.1000; 100 | 0.1000; 100 | |
| δ-gluconolactone (GDL) 48 mM [% (w/w); m (mg)] | 0.8600; 860 | 0.8600; 860 | |
| Ultrapure water [% (w/w); m (mg)] | 97.54; 97,540 | 97.43; 97,430 | |
| TOTAL [% (w/w); m (mg)] | 100; 100,000 | 100; 100,000 | |
Disclaimer/Publisher’s Note: The statements, opinions and data contained in all publications are solely those of the individual author(s) and contributor(s) and not of MDPI and/or the editor(s). MDPI and/or the editor(s) disclaim responsibility for any injury to people or property resulting from any ideas, methods, instructions or products referred to in the content. |
© 2024 by the authors. Licensee MDPI, Basel, Switzerland. This article is an open access article distributed under the terms and conditions of the Creative Commons Attribution (CC BY) license (https://creativecommons.org/licenses/by/4.0/).
Share and Cite
Vila, M.M.D.C.; Cinto, E.C.; Pereira, A.O.; Baldo, D.Â.; Oliveira Jr., J.M.; Balcão, V.M. An Edible Antibacterial Coating Integrating Lytic Bacteriophage Particles for the Potential Biocontrol of Salmonella enterica in Ripened Cheese. Polymers 2024, 16, 680. https://doi.org/10.3390/polym16050680
Vila MMDC, Cinto EC, Pereira AO, Baldo DÂ, Oliveira Jr. JM, Balcão VM. An Edible Antibacterial Coating Integrating Lytic Bacteriophage Particles for the Potential Biocontrol of Salmonella enterica in Ripened Cheese. Polymers. 2024; 16(5):680. https://doi.org/10.3390/polym16050680
Chicago/Turabian StyleVila, Marta M. D. C., Edjane C. Cinto, Arthur O. Pereira, Denicezar Â. Baldo, José M. Oliveira Jr., and Victor M. Balcão. 2024. "An Edible Antibacterial Coating Integrating Lytic Bacteriophage Particles for the Potential Biocontrol of Salmonella enterica in Ripened Cheese" Polymers 16, no. 5: 680. https://doi.org/10.3390/polym16050680
APA StyleVila, M. M. D. C., Cinto, E. C., Pereira, A. O., Baldo, D. Â., Oliveira Jr., J. M., & Balcão, V. M. (2024). An Edible Antibacterial Coating Integrating Lytic Bacteriophage Particles for the Potential Biocontrol of Salmonella enterica in Ripened Cheese. Polymers, 16(5), 680. https://doi.org/10.3390/polym16050680

